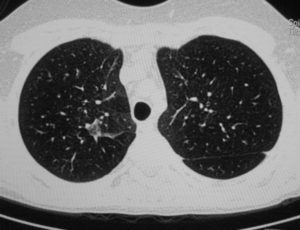
КТ грудной клетки. Астма или нет?

Что показывает КТ грудной клетки, подготовка, показания и противопоказания
Компьютерное сканирование помогает установить диагноз в самых сложных случаях
КТ органов грудной клетки — усовершенствованный способ рентгенографической визуализации, который использует излучение для создания детальных изображений грудины, грудино-ключичных суставов, ребер, прилежащих мягких тканей и органов (в первую очередь, легких).
Исследование проводят, если после выполненной обычной рентгенографии причина жалоб осталась неясной или есть подозрение на патологический процесс в данной области.
Компьютерная томография органов грудной клетки может быть выполнена в качестве альтернативы МРТ, если у пациента есть противопоказания к проведению магнитно-резонансного сканирования. Для лучшей визуализации возможно введение контрастного вещества.
Основным преимуществом КТ является его способность одновременно демонстрировать кости, мягкие ткани (при контрастировании) и кровеносные сосуды.
Что показывает КТ грудной клетки
Мультиспиральная КТ грудной клетки, 3D-реконструкция
Специалисты выделяют в средостении три области: центральное (сосудистое пространство с перикардом и его содержимым, сосудами и лимфатическими узлами), переднее (жировая клетчатка, вилочковая железа, внутренние грудные артерии и лимфоидные ткани) и заднее (трахея, пищевод, нисходящая часть грудной аорты, лимфоузлы и паравертебральные пространства грудной клетки). Соответственно, все патологические процессы, которые протекают в данных зонах, могут быть видны.
Грудина, ребра и их сочленения — основные структуры передней стенки грудной клетки — подвержены различным анатомическим аномалиям и патологическим процессам, которые в некоторых случаях требуют лечения.
Врач обосновано направит на диагностическую процедуру, если у пациента имеет место необъяснимый длительный кашель, загрудинные боли, кровохарканье, увеличение регионарных лимфоузлов, ограничение в движении плеча, скованность в области грудного отдела позвоночника и др.
КТ органов грудной клетки и средостения может показать следующие изменения:
- Дегенеративно-дистрофические заболевания.
Остеоартроз (остеоартрит) — распространенная патология, затрагивающая чаще грудино-ключичные суставы.
На компьютерной томограмме, в отличие от рентгенограммы, можно увидеть субхондральный склероз, кисты, сужение суставной щели и изменения в волокнистой хрящевой ткани диска.
Серонегативные артриты, подагра и некоторые иные заболевания также могут затрагивать соединения отделов грудины между собой и с окружающими костными структурами, что убедительно видно на КТ.
Ранняя диагностика септического артрита грудино-ключичного сустава важна для своевременного начала лечения, так как существует высокий риск осложнений — целлюлита, остеомиелита, медиастинита, септического шока. В запущенных случаях можно увидеть абсцесс и формирование свищевого хода.
Изменения, которые видны при КТ органов грудной клетки, включают воспалительные процессы в твердых структурах (разрушение суставных поверхностей, расширение суставной щели), в органах и тканях (диффузная инфильтрация, скопление жидкости, газа, размытость границ, реактивное увеличение лимфоузлов).
Осложнившуюся пневмонию, плеврит, абсцесс легкого и мягких тканей грудной клетки можно диагностировать с помощью КТ. Исследование также показывает изменения со стороны сердца и клапанного аппарата.
- Острые и травматические состояния.
В результате сильного физического воздействия (чаще — вследствие ДТП) возникают один или несколько переломов грудины. Компьютерная томография позволяет диагностировать сочетанные травмы (повреждения ребер, грудного отдела позвоночника, легких и сердца) и осложнения (легочные ателектазы, гемо- и пневмоторакс, гемоперикард).
Спонтанные переломы грудины возникают при наличии новообразования (множественная миелома, метастазирование), остеопороза и могут имитировать острые коронарные заболевания. С помощью КТ грудной клетки возможна диагностика врожденных аномалий сосудов или приобретенных патологий: тромбоэмболии легочной артерии, диссекции аорты и пр.
По данным КТ ОГК выявляют причины ишемии, дисфункцию сердечных клапанов.
- Послеоперационные осложнения.
После выполнения стернотомии (операция обеспечивает лучший доступ к сердцу) есть вероятность осложнений: расхождения краев раны, вторичный остеомиелит грудины или ребер, медиастинит и медиастинальная гематома, плевральный выпот.
После хирургических вмешательств на сердце и сосудах могут развиться неблагоприятные последствия (инфицирование электродов кардиостимулятора, инфекционно-воспалительные осложнения и пр.). Эти состояния с помощью КТ дифференцируют с нормальными послеоперационными изменениями. У таких пациентов выполняют компьютерное сканирование в динамике.
Осложнения могут присутствовать и после вмешательств на легких и прочих структурах. В экстренных ситуациях преимущество КТ — быстрота получения результатов.
- Новообразования и метастазирование.
Большинство неопластических процессов грудины носит метастатический характер, что объясняется прямым проникновением из соседних органов или гематогенным путем.
Рак молочной и щитовидной желез, легкого, почки, толстой кишки и лимфомы — самые распространенные источники метастазов грудины.
КТ грудной клетки с контрастом — золотой стандарт в диагностике рака легких, позволяет увидеть изменения на начальной стадии, при которой возможно радикальное лечение.
Компьютерное сканирование показывает также новообразования средостения, которые многообразны по морфологии и генезу. Наиболее часто встречаются тимомы, кисты, нейрогенные опухоли, злокачественные лимфомы. С помощью сканирования при дисфагии можно предположить рак пищевода, но во всех случаях окнчательный диагноз подтверждает морфологическое исследование.

Нередко пациенты задают вопрос: “Что сделать — КТ или МРТ органов грудной клетки?” К каждому исследованию есть свои показания и противопоказания, но способы часто являются взаимодополняющими. Специалисты диагностического центра могут подсказать, что предпочтительнее в каждом конкретном случае, но лучше, если на руках будет направление от лечащего врача.
Как делают КТ органов грудной клетки
Положение пациента во время КТ грудной клетки
На диагностическую процедуру необходимо предварительно записаться, но возможно выполнение в день обращения, по жизненным показаниям. Современные КТ-сканеры могут исследовать большие участки тела всего за несколько секунд, что особенно подходит для пациентов, испытывающих трудности с длительной неподвижностью и маленьких детей.
Рентген-техник размещает пациента на столе, для обеспечения неподвижности возможно использование фиксирующих ремней и подушек. Излишняя мобильность приводит к появлению размытости на изображениях. Наблюдение за ходом процедуры ведется из смежного кабинета, через стекло. Для экстренных случаев есть кнопка связи с персоналом.
Стол с пациентом скользит вглубь томографа, вокруг тела начинает вращаться множество рентгеновских датчиков, передавая изображения поперечного сечения грудной клетки на экран монитора. Снимки с помощью специальной компьютерной программы могут быть переформатированы в другие плоскости.
Полученные в результате диагностики данные легко перенести на любой носитель или распечатать. Неприятных ощущений во время КТ органов грудной клетки и средостения нет, технический шум, который производит работающее оборудование, можно нивелировать, если воспользоваться наушниками.
Сканирование длится менее минуты, вся процедура с подготовкой и укладкой занимает не более получаса.
Для улучшения визуализации в некоторых случаях (преимущественно, в диагностике злокачественных новообразований и для оценки динамики после проведения химиолучевой терапии) выполняют КТ органов грудной клетки с контрастом.
Препарат вводят внутривенно, перед этим обязательно оценивают уровень креатинина в крови.
Усиленная радиофармпрепаратом компьютерная томография помогает уточнить диагноз при туберкулезе (количество очагов, их расположение, состояние лимфоузлов), но окончательная верификация происходит после оценки результатов комплексного обследования (пробы Манту, диаскинтеста, и, при необходимости, биопсии). Воспаление и повреждение паренхимы легких обычно хорошо видны на КТ без контрастного усиления. Если есть опасения по поводу осложнений, радиофармпрепарат может помочь дополнительно определить степень выраженности патологического процесса.
КТ органов грудной клетки детям проводят исключительно по жизненным показаниям в специальных диагностических центрах при педиатрических клиниках.
Подготовка к исследованию
Перед прохождением диагностики убедитесь в отсутствии противопоказаний
Каких-либо длительных мероприятий подготовка к КТ грудины не подразумевает, для нативного исследования достаточно выбрать удобную одежду без металла, снять украшения.
Если предстоит введение контрастного вещества, за 40-50 минут до начала процедуры необходимо неплотно перекусить, что поможет предотвратить или уменьшить вегетативные реакции (легкую тошноту, слюнотечение, головокружение).
Пациенты, страдающие сахарным диабетом и принимающие Метформин, по согласованию с эндокринологом должны отказаться от препарата за 48 часов до процедуры. Во время лактации рекомендуют сделать запас молока на два кормления.
Показания и противопоказания к КТ грудины
КТ грудины входит в компьютерное сканирование грудной клетки. Диагностика не является рутинным методом обследования и выполняется, если причина заболевания остается неясной или изменения на рентгенограммах требуют уточнения.
Перечислим основные показания к КТ грудины и грудной клетки:
- подозрение на патологический процесс в легких, плевре, сердце, грудине, суставах, средостении;
- посттравматическая диагностика;
- пред- и послеоперационное обследование;
- определение зоны для лучевого воздействия при злокачественных новообразованиях соответствующей области;
- отслеживание динамики после проведенного лечения.
Противопоказания к КТ грудины и грудной полости
Современная аппаратура позволяет минимизировать лучевую нагрузку по сравнению с обычной рентгенографией в 1,5-2 раза: КТ ОГК безопасна для большинства людей. Исключение — беременные женщины и дети в возрасте до 14 лет. По техническим причинам диагностическая процедура невыполнима у пациентов с выраженным ожирением (выше 150 кг).
Противопоказания к выполнению контрастирования:
- хроническая почечная недостаточность с повышением уровня креатинина;
- гипертиреоз;
- поливалентная аллергия.
Введение индикаторного препарата недопустимо, если во время или после предыдущего контрастирования развилась серьезная реакция гиперчувствительности по типу отека Квинке или анафилаксии. Небольшая тошнота, металлический привкус, головокружение, приливы жара рассматриваются как вариант нормы и не являются противопоказаниями к КТ с усилением.
Расшифровка снимков происходит в тот же день. Полученные изображения анализирует врач-рентгенолог, который и выдает заключение. Определить верный диагноз непросто, ведь среди нескольких десятков оттенков черного, серого и белого необходимо вычленить несоответствующий норме и интерпретировать результат. Представим Вашему вниманию несколько фото томографии грудной клетки:
КТ без контраста у пациента с интерстициальным заболеванием легких в анамнезе и трансплантацией правого легкого показывает суженный участок анастомоза правого бронха (красная стрелка). Собственное левое легкое уменьшено в размерах, с признаками бронхоэктазов, бронхиолоэктазов (черная стрелка). Сужение центрального дыхательного пути на выдохе у трансплантированного легкого (синяя стрелка).
Выпот (красные стрелки) в обеих плевральных полостях.
В диагностическом центре “Магнит” в Санкт-Петербурге можно сделать КТ органов грудной клетки, предварительная запись через форму сайта или по телефону: +7 (812) 407-32-31.
Кт легких: что это такое и что показывает; как делают
Компьютерная томография (КТ) легких — современный метод выявления заболеваний легких, основанный на фиксации рентгеновского излучения при прохождении их через грудную клетку человека. Процедура позволяет обнаружить различные заболевания и патологические процессы в легочной ткани. Метод имеет обширный список показаний. Однако, решение о его проведении всегда принимает врач.
Что показывает КТ легких
При проведении компьютерной томографии, врач может оценить состояние и структуру ткани легкого, бронхов, медиастинальных лимфатических узлов, кровеносных сосудов и аорты. Благодаря этому, КТ позволяет выявлять любые патологические процессы в указанных структурах, как очагового, так и диффузного характера.
Специалист видит на полученных снимках характер патологии, ее распространенность, степень повреждения легких и локализацию изменений. На КТ грудной клетки можно оценить не только легкие, но и плевру, мышечные структуры, подкожную жировую клетчатку и молочные железы.
Костные структуры видны частично, так как сканирование происходит в продольной плоскости.
Легкие — сложно устроенные органы. При компьютерной томографии оценивается их плотность, ветвление и размеры бронхов, а также состояние кровеносных сосудов.
Врач может выявить очаговые образования в виде кист, метастазов, первичных опухолей и расширений бронхиального дерева. Диффузные изменения наблюдаются при воспалительных процессах.
На плевре возможны спайки, фиброзные наложения, участки обызвествления, а также скопления жидкости, крови или воздуха в плевральной полости.
Преимущества компьютерной томографии по сравнению с другими диагностическими процедурами (УЗИ, МРТ и пр.):
- процедура занимает от 5 до 30 минут. Последующая расшифровка результатов проводится врачом в течение часа;
- объективные результаты, отражающие состояние легких, их нормальную структуру или патологические процессы;
- отсутствие боли, так как сканирование полностью неинвазивно;
- суммарная доза ионизирующего облучения низкая и не может причинить вред пациенту;
- КТ позволяет получить качественные трехмерные изображения легких, что обеспечивает высокую точность диагностики и низкий риск появления ложных результатов.
Важно! Расшифровку снимков должен проводить только специалист. В противном случае возможна постановка неправильного диагноза и прогрессирование основной патологии.
Результаты: нормы и патология
КТ легких в отсутствии патологий имеет характерные признаки: органы нормальной структуры без каких-либо очаговых или диффузных изменений. Трахея и главные бронхи сохраняют свое анатомическое строение.
Свободная жидкость в плевральной полости отсутствует. Средостение обычной ширины и без патологических процессов в лимфатических узлах. Грудная стенка не изменена.
Просвет аорты, легочных артерий и легочного ствола без тромботических масс.
Патология в легких может иметь различный вид. Это зависит от конкретного заболевания, стадии болезни и индивидуальных особенностей человека.
Как правило, для постановки точного диагноза требуется одновременная оценка изменений на КТ, клинических симптомов и проведение дополнительных методов обследования.
К основным патологиям, наблюдаемым в легких, относят: туберкулез, опухоли, бронхит и пневмонию.
Опухоль проявляется в виде очага размером от 10 мм и более. Она имеет плотную, но не однородную структуру, и отчетливо выделяется на фоне легочной ткани. Новообразования в легком могут расти внутри бронхов. В этом случае, врач видит объемные структуры в бронхиальном просвете, которые частично перекрывают его, или же могут расти в окружающие ткани.
Туберкулез у людей протекает в нескольких формах, которые имеют структурные отличия. При первичном туберкулезном комплексе в легких появляется округлая тень, имеющая нечеткие органы.
Корень легкого расширяется и он соединяется с первичным очагом линейной тенью в виде тонкой «дорожки». Если у больного имеется очаговый туберкулез, то в верхушках легкого появляются округлые тени, которые могут быть единичными или множественными.
Инфильтративная форма патология проявляется на КТ-снимках затемнениями различной формой с нечеткими контурами и выраженным инфильтратом.
Пневмония имеет вид участков уплотнения с неоднородной структурой и нечетким контуром. При этом, отчетливо видны ненарушенный просвет бронха. Пневмония часто сопровождается изменениями плевры — она утолщается, что связано с развитием в ней воспалительного процесса.
Острый бронхит — распространенное заболевание, которое встречается у больных различного возраста. Патологические изменения располагаются в бронхах, которые обеспечивают воздушную проводимость легких. В области пораженной ткани возникают очаговые инфильтраты, которые сопровождаются усилением легочного рисунка. Томография позволяет уточнить локализацию и распространенность поражения.
Обследование позволяет выявить и другие патологические процессы: плеврит (воспалительное поражение плевры), абсцесс (полость, заполненная гноем) и др. При этом, КТ обладает большей точностью по сравнению с аналогичными методами. Благодаря этому, томографию используют для выявления заболеваний органов дыхательной системы.
Как делают исследование КТ легких
Пациенты часто задаются вопросом, какой врач назначает компьютерную томографию. Основный специалист, который выбирает методы обследования органов дыхательной системы — пульмонолог. Он определяет имеющиеся у человека показания и противопоказания, подбирая оптимальные методы лабораторных и инструментальных исследований.
Перед проведением компьютерной томографии пациент снимает все металлические предметы, в том числе, часы, заколки, украшения, пирсинг, а также убирает гаджеты.
Это позволяет избежать появления артефактов на КТ-снимках. После этого, с человеком беседует медицинский работник.
Он объясняет правила и ход проведения сканирования легких, и показывает, как можно связаться с врачом при необходимости.
Пациента помещают на кушетку томографа в положении на спине и заводят руки за голову. После размещения человека, включается аппарат. Кушетка начинает перемещаться в горизонтальной плоскости.
В это время лучевая трубка и детекторы работают по заданной программе. Медицинский работник периодически просит больного задержать дыхание. Это позволяет лучше рассмотреть легочную ткань.
При необходимости вводятся контрастные вещества.
В отличии от МРТ, КТ длится недолго — от 5 до 20 минут. По завершению процедуры, кушетка переходит в начальное положение. Медицинская сестра помогает снять все фиксирующие приспособления у пациента. После этого, он ждет результатов обследования.
Виды обследования
В медицине выделяют три типа компьютерной томографии: шаговую, спиральную и мультиспиральную. Также, исследование может проводить с контрастным веществом или без него.
Шаговая рентгеновская томография легких является первой разновидностью КТ. Во время процедуры, кушетка с пациентом двигается внутри аппарата на определенное расстояние.
При каждой остановке, аппарат совершает рентгеновский снимок. Т.е., создаются послойные снимки-срезы легких, которые затем обрабатываются компьютером. Время обследования — 20-30 минут.
Метод имеет высокую информативность и используется в большом количестве клиник.
Компьютерная спиральная томография легких имеет два отличия: кушетка двигается постоянно, а лучевая трубка совершает движение вокруг тела по спирали.
Благодаря этому, врач получает более точное изображение органов грудной клетки, а продолжительность обследования сокращается. Спиральный тип КТ позволяет обнаружить минимальные изменения в легочной ткани.
Он имеет оптимальное соотношение цена/качество.
Мультиспиральная КТ характеризуется тем, что напротив рентгеновской трубки имеется несколько рядов детекторов. Это повышает точность диагностики, но увеличивает ее стоимость. Благодаря нескольким детекторам, метод сравним с МРТ по визуализации органов грудной клетки. Мультиспиральное обследование считается наиболее современным и информативным в медицине.
Любой тип КТ исследования может проводится с контрастом. Благодаря его введению, врач может оценить кровеносное русло, бронхи и др. В медицине используют безопасные для больных контрасты, которые растворимы в воде и выводятся из организма вместе с мочой.
Показания — противопоказания
КТ легких проводится по определенным показаниям. Благодаря этому, снижается вред рентгеновского облучения и не возникает гипердиагностика заболеваний органов грудной клетки. К основным показаниям для выполнения компьютерной томографии относят:
- симптомы опухолевого или метастатического поражения трахеи, бронхов, средостения или легочной паренхимы;
- дифференциальная диагностика между доброкачественными и злокачественными новообразованиями;
- определение стадии и степени распространения опухолевой ткани на КТ срезах;
- диагностика острых и хронических заболеваний легких: пневмонии, туберкулеза, саркоидоза, пневмосклероза, эмфиземы, ХОБЛ, альвеолита, бронхиолита и т.д.;
- симптоматика плеврита или эмпиемы плевры;
- длительно сохраняющиеся симптомы заболеваний легких в виде одышки, кашля, повышенной температуры тела и боли в грудной клетки при отрицательных результатах других методов обследования;
- поиск аномалий строения бронхов, легких, артериальных и лимфатических сосудов, а также других органов грудной клетки;
- травмы грудной клетки. КТ позволяет исключить пневмоторакс, гидроторакс, гемоторакс и разрыв легкого.
Компьютерная томография, как и МРТ подходит для выявления любых патологических процессов в органах грудной полости — от злокачественных новообразований до нарушений кровотока в сосудах легкого.
Противопоказания к проведению КТ делят на две группы: в случае использования контраста и без него. Если контраст не вводится, то сканирование не проводят при:
- любом сроке беременности;
- возрасте пациента меньше 14 лет;
- неадекватном поведении больного.
При наличии у человека протезов, имплантов или металлических конструкций, исследование проводится, однако, но снимки будут иметь низкое качество.
При использовании контраста, список противопоказаний больше:
- аллергические заболевания с тяжелым течением, в том числе, бронхиальная астма;
- индивидуальная непереносимость и аллергия на йод;
- тяжелая почечная или печеночная недостаточность;
- возраст до 14 лет и старше 70 лет;
- опухолевые заболевания щитовидной железы и гипертиреоз;
- феохромоцитома;
- длительный прием бета-адреноблокаторов, нестероидных противовоспалительных средств и мочегонных препаратов;
- прием йодсодержащих средств за день до процедуры.
Больные интересуются тем, как часто можно делать компьютерную томографию легких. Ограничения связаны с вредом и дозой облучения, которую получает пациент во время каждого сканирования. Оптимальный промежуток между двумя обследования — 6-12 месяцев. У больных с опухолями легкого, КТ может проводиться чаще по медицинским показаниям.
Подготовка
Получить качественные результаты сканирования тела при КТ-исследовании можно при правильной подготовки пациента. Простая компьютерная томография не требуют специфического подхода к образу жизни, однако, если планируется использовать контрастные вещества, то следует обсудить вопросы питания.
За 6-8 часов до сканирования следует отказаться от приема пищи. Это позволяет избежать тошноты и рвоты во время исследования. Также, за 2-3 дня до КТ рекомендуется исключить из питания продукты и блюда, способствующие развитию метеоризма. Большое количество свободного воздуха в кишечнике может привести к подъему диафрагмы и появлению на снимках артефактов.
Перед самим проведением, человек снимает с себя часы, аксессуары (часы, заколки, украшения), зубные протезы и др. После этого, он надевает больничный халат. Врач беседует с ним и рассказывает о предстоящей процедуры.
КТ, в отличие от МРТ выполняется быстро, что позволяет уменьшить дискомфорт для пациента, однако, понимание процесса обследования снижает стресс. После того, как больной располагается на кушетке, медсестра подкладывает валик под шею и фиксирует руки.
Это позволяет избежать движений телом и «смазывание» снимков.
Во время проведения сканирования врач находится в соседнем кабинете и отслеживает ход процедуры. Это позволяет избежать ошибок во время КТ и контролировать состояние пациента.
Фото КТ легких
Инфильтративный туберкулезЕдиничный цилиндрический бронхоэктаз (бронхит)
Стоимость
Цена на исследование легких зависит от конкретного города и диагностического центра. Стоимость на сканирование без контраста — от 1500 до 3000 рублей.
За процедуру с введением контрастного вещества придется заплатить более 3 тыс рублей. По медицинским показаниям (подозрения на опухоль легкого, пороки развития и др.
) исследование может быть выполнено бесплатно за счет средства Фонда ОМС.
Кт легких и бронхов — что показывает и как делается обследование
Компьютерная томография легких сейчас признается самым информативным методом, позволяющим обнаружить заболевания органов дыхания на ранних стадиях.
Снимки КТ очень точны, отражают малейшие отклонения в структуре легочной ткани и сосудов, бронхов, а также трахеи и ряда других органов.
В статье пойдет речь о том, каковы показания к КТ легких и ограничения на выполнение, как именно делают обследование и какие результаты можно получить.
Компьютерная томография легких – виды и их описание
Что такое КТ легких и бронхов, знают многие пациенты современных клиник, где эта методика применяется порой чаще, чем рентгеновское исследование. Любая КТ использует те же самые рентгеновские лучи, но в намного меньшем количестве, поэтому облучение, получаемое пациентом, минимальное. Сейчас существует три основных разновидности томографии органов грудной клетки:
- Обычная КТ. Это обследование проводится при помощи томографов, сканирующих выбранный орган по срезам, после чего делается компьютерная обработка данных и анализ результатов. Есть два режима такой процедуры – легочный (показывает бронхи, сосуды, патологические очаги в легких) и режим сканирования прочих органов грудной клетки (сосудов, средостения, сердца и т.д.).
- Спиральная КТ. Датчики аппарата, сканирующего легкие, движутся по спирали, вращающейся вокруг стола. Исследование длится намного меньше, чем описанное выше, при этом результаты еще более точные. Если же применяется мультисрезовая (мультиспиральная) КТ, то толщина среза не превышает миллиметра, следовательно, на трехмерных картинках можно разглядеть даже мельчайшие опухоли и прочие патологии.
- КТ с контрастированием. Перед осуществлением обследования пациенту вводят специальное контрастное (окрашивающее) вещество, которое позволит хорошо визуализировать строение и функцию сосудистой сети в области грудной клетки. Контраст усилит обратный сигнал от стенок артерий и вен, поэтому изображения получатся еще более четкими, информативными. Поскольку данный метод применяется, преимущественно, для диагностики состояния вен и артерий, его называют еще КТ-ангиографией.
Несмотря на минимум лучевой нагрузки, томография легких должна проводиться только по показаниям, и без рекомендаций врача делать ее недопустимо.
Как часто можно осуществлять процедуру, будет зависеть от конкретной дозы полученного излучения, возраста и состояния здоровья человека, от срока давности проведения предыдущего исследования (все данные обязательно указываются на расшифровке к снимкам). Обычно не рекомендуется делать процедуру чаще 2-х раз в год.
Показания к выполнению процедуры
Обычный томограф в настоящее время широко применяется для диагностики инфекционных легочных заболеваний, в частности, при туберкулезе, подозрении на пневмонию, бронхит. Что показывает КТ легких в режиме сканирования органов средостения? Это – полная оценка состояния:
- Трахеи
- Сердца
- Лимфоузлов
- Аорты
- Верхней полой вены
- Легочной артерии
- Диафрагмы
- Вилочковой железы
- Частично — пищевода
При подозрении на патологию указанных органов можно применять данное исследование. В легочном режиме оно позволит изыскать любые патологические очаги в ткани легких, выяснить состояние главных, сегментарных, долевых бронхов, межсегментарных перегородок, строение сосудов легких.
Кт органов грудной клетки — все о процедуре
По снимкам можно дифференцировать опухоли доброкачественного характера от злокачественных, от очагов туберкулеза, выявить абсцессы и свищи. Если имеется раковое новообразование, томография легких отразит его размер и стадию, распространенность, ближайшие метастазы. КТ назначают всем, у кого увеличены грудные или ключичные лимфоузлы, есть неясные боли в области легких, грудной клетки.
https://youtube.com/watch?v=Fy0BRLKz3GQ
Качество снимков, полученных от спиральной и мультиспиральной КТ, еще выше. Такие методы диагностики позволят выявить даже малейшие изменения в дыхательной системе, поэтому нередко рекомендуются для уточнения диагноза после менее информативных методов.
Также методы пригодятся перед операцией, для оценки качества лечения, после проведенного хирургического вмешательства. Незаменимо исследование при травме грудной клетки, попадании внутрь инородного тела, при подозрении на наличие жидкости в полости плевры.
Что касается состояния сосудов, то КТ-ангиография показана больным с подозрением на:
- Нарушение проходимости сосудов
- Сужение, излишнее расширение вен и артерий
- Мальформации (сосудистые аномалии)
- Наличие тромбов, сгустков, жировых бляшек
Таким образом, томография легких необходима для диагностики большинства из известных заболеваний органов грудной клетки. Именно этот метод в последние годы позволяет обнаружить рак (карциному) легкого на ранней стадии и спасти жизнь больному.
Как проводится обследование?
Как и другие виды томографии, данная процедура неинвазивна, безболезненна для человека, несет малую опасность для здоровья.
Длительность обследования варьирует от нескольких минут до получаса, что зависит от сложности проблемы и вида томографа.
МСКТ легких обычно назначают к выполнению пациентам в тяжелом положении, например, во время реанимационных мероприятий, поскольку продолжительность процедуры – около 5-10 минут.
Подготовка к обследованию несложна. Обычно рекомендуется придти в клинику натощак, не кушая хотя бы 3-4 часа. Одежда должна быть свободной, чтобы движения не стеснялись. Если у человека имеется клаустрофобия, прочие психические отклонения, до процедуры ему может быть выполнена седация или наркоз.
Порядок прохождения самой процедуры таков:
- Пациент снимает металлические украшения, ремень, раздевается до пояса, ложится на кушетку.
- При необходимости, в вену вводится контраст.
- Кушетку помещают в нужное положение под аркой томографа.
- Специалист выходит в соседнее помещение, плотно закрывает дверь. Отсюда он наблюдает за пациентом.
- Человек должен лежать без малейшего движения, что позволит получить самую точную информацию.
- По завершению процедуры пациент встает (после прихода медработника), ожидает в коридоре до получения расшифрованного результата.
Никакого дискомфорта, кроме небольшого треска в ушах, человек не услышит. Во многих клиниках в руку дают «грушу», при сжатии которой специалисты услышат сигнал и прекратят обследование (в экстренном случае).
Кому противопоказана КТ?
Противопоказания к исследованию такие:
- Беременность любого срока
- Лактация (КТ возможна с отлучением от груди минимум на сутки)
- Детский возраст до 3 лет (детям 3-10 лет процедуру делают только при наличии серьезных показаний)
- Вес более 170-200 кг (относительное противопоказание, зависит от типа аппарата)
- Клаустрофобия, эпилепсия, другие психические расстройства
КТ-ангиография может быть воспрещена при аллергии на контрастное вещество.
Если оно содержит йод, то томография противопоказана при гипертиреозе, других патологиях щитовидной железы, миеломной болезни, запущенной стадии сахарного диабета, сердечной недостаточности, почечной недостаточности.
Перенести диагностику придется, если за несколько дней уже выполнялись любые исследования с применением висмута и бария – они могут отрицательно повлиять на расшифровку итогов томографии.
Результаты сканирования грудной клетки
После получения качественных снимков КТ врач-рентгенолог подробно их изучает и обращает внимание на:
- Плотность легочной ткани по сегментам
- Наличие или отсутствие гранулем, опухолей
- Размеры патологических участков
- Характер кровообращения и т.д.
Обычно в расшифровке отмечается, что описание КТ диагнозом не является. Точный диагноз поставит врач, направивший на обследование – терапевт, пульмонолог, фтизиатр.
Заболевания, при которых рекомендуют КТ легких
- Расслоение аорты
- Пороки сердца (обзорно)
- Эмфизема
- Бронхоэктазы
- Хронический и острый бронхит
- Пневмония
- Обструктивный бронхит
- Бронхиальная астма
- Опухоли легких, средостения
- Инородные тела
- Гнойное расплавление легочной ткани
- Болезни вилочковой железы
- Перикардит
- Переломы ребер
- Аневризмы аорты и артерий
- Аномалии строения аорты, вен и артерий
- Тромбоз и тромбоэмболия
- Атеросклероз легочных артерий
- Ишемическая болезнь сердца
Томография легких, как правило, дает исчерпывающий результат в диагностике проблем органов грудной клетки. Цена ее обычно составляет 1800-3600 руб. в зависимости от типа аппарата и необходимости в контрастировании, поэтому метод является быстрым, доступным и эффективным.
Рентген при бронхиальной астме: виды исследования и результаты
Одним из распространенных заболеваний органов дыхательной системы является бронхиальная астма. Помимо выявления характерной симптоматики, для подтверждения диагноза необходим ряд инструментальных исследований.
Обязательным условием комплексного обследования является спирограмма, тесты для оценки функций дыхания и т. д. Проведение рентгена органов дыхания при бронхиальной астме позволяет отличить ее от других заболеваний при дифференциальной диагностике.
Поэтому обязательным является прохождение рентгенологического исследования у профильного специалиста.
Бронхиальная астма
Различают неосложненную и осложненную форму астмы. В первом случае для подтверждения диагноза, как правило, достаточно выявления характерной симптоматики и осмотра врача.
Осложненная бронхиальная астма требует комплексного обследования с элементами дифференциальной диагностики.
Данное заболевание относится к патологиям органов дыхательной системы и сопровождается следующими признаками:
- приступы удушья в ночное время;
- болевые ощущения и давление в области грудной клетки;
- лающий кашель;
- частая отдышка даже в состоянии покоя (связано с нарушением дыхательного процесса);
- в положении лежа свистящие звуки при выдохе воздуха.
Несвоевременное лечение повышает шансы на переход астмы в более тяжелую стадию[М8] . В таком случае у пациента чаще развиваются обострения при воздействии негативных факторов (стрессы, погодные условия и т. д.).
Важность дифдиагностики при астме
При постановке диагноза очень важно дифференцировать болезнь от схожих по симптоматике патологий (инфекции органов дыхания, аллергия и т. д.), чтобы назначить правильное лечение.
Для этого, помимо рентгенологического исследования, пациенту проводят обязательную оценку работы легких. Этот вид исследований называется спирометрией. Больному надевают на нос специальный зажим, а в рот вставляют трубку (в нее человек дышит).
По команде врача пациент делает максимально глубокий вдох, затем резкий выдох. При этом оцениваются функции внешнего дыхания, и на основе их показателей подтверждается или опровергается диагноз бронхиальной астмы.
Рентгенологические исследования при астме
Одним из часто назначаемых исследований органов грудной клетки является рентген. На снимке четко отображается структура легких и бронхов, видны возможные отклонения от нормы.
Рентгенография грудной клетки и диафрагмы отличается простотой и безболезненностью.
Сегодня используются современные приборы, которые позволяют вывести полученное изображение на экран монитора компьютера и оценить состояние больного сразу после процедуры.
Рентгенологические исследования требуются для диагностики осложненной формы бронхиальной астмы.
Рентгенография
Рентгенография считается наиболее достоверным исследованием при диагностике патологий органов дыхательной системы. При проведении процедуры пациент не ощущает никакого дискомфорта, полученный снимок дает возможность оценить состояние легких и бронхов, выявить возможные патологические процессы.
Сегодня существуют несколько вариантов рентгенографии: результаты выводятся непосредственно на экран монитора или распечатываются на пленке. Недостатком такого исследования считается воздействие облучения.
Поэтому рентген назначают нечасто и в крайних случаях, когда другие методы диагностики недостаточно информативны.
Рентгенограмма помогает определить начальные стадии многих патологий органов дыхательной системы, в том числе и эмфизему легких. В период обострения астмы на полученном снимке четко прослеживаются следующие аномалии:
- поля легких имеют прозрачную структуру;
- купол диафрагмы немного уплотнен;
- подвижность ребер сильно ограничена;
- контуры сердца прослеживаются нечетко.
Стоит отметить, что легкая форма астмы не всегда прослеживается на рентгеновском снимке. По мере развития более тяжелой стадии астмы врач может поставить диагноз, исходя из изменений в структуре легких (но не бронхов).
Флюорография
Это одна из разновидностей рентгенологической диагностики. Флюорография дешевле рентгеновского снимка, ее можно сделать в любой поликлинике.
Каждый человек, проходя ежегодный профилактический осмотр, получает у терапевта направление на флюорографию. Своевременная диагностика помогает выявить патологии на ранних стадиях (очень часто болезни протекают без видимой симптоматики).
При постановке диагноза «бронхиальная астма» флюорографическое обследование назначается редко. Однако этот метод позволяет выявить патологии легких даже при отсутствии характерной симптоматики.
Если пациент получает неудовлетворительные результаты флюорографического снимка, то его направляют на дополнительное обследование.
Рентгеноскопия
Считается более информативным методом диагностики при астме, чем обычный рентгеновский снимок. На экране монитора врач может проследить за движениями грудной клетки и диафрагмы пациента во время вдохов и выдохов.
https://youtube.com/watch?v=zN2s4Ya_OWk
Результат рентгеноскопии информативнее, структуру органов можно рассмотреть более подробно.
Такой вид исследования очень актуален для получения информации в режиме реального времени. Экстренная рентгеноскопия назначается пациенту при необходимости срочного хирургического вмешательства.
Больному вводят специальное контрастное вещество (чаще всего это сульфат бария), которое позволяет детально выявить возможные аномалии.
Показания для рентгенологического исследования
Пациенту в обязательном порядке назначат рентген при подозрении на бронхиальную астму. Это касается и осложненной, и неосложненной формы заболевания.
Во втором случае диагностика помогает исключить возможные осложнения и сопутствующие патологии (туберкулез, пневмония, обструктивный бронхит хронической формы, посторонние тела в бронхах и т. д.).
Рентген не требует специальной подготовки от пациента и врача. Процедуру назначают также в экстренных случаях, когда больному требуется оказание неотложной медицинской помощи.
Человеку стоит обратиться к специалисту при частых приступах кашля, которые сопровождаются отдышкой и другими симптомами, характерными для бронхиальной астмы. Ранняя диагностика поможет своевременно выявить наличие осложнений и избежать нежелательных последствий.
Рентгенологическая картина при астме
Постановкой диагноза обязательно должен заниматься профильный специалист. Не всегда отдышка и приступы кашля свидетельствуют о развитии бронхиальной астмы.
Часто такие симптомы возникают при обструктивном бронхите тяжелого течения. Помимо рентгенодиагностики, больному обязательно назначат лабораторные анализы крови и бактериологический посев мокроты (для исключения туберкулеза).
Признаком астмы при рентгеноскопии является учащение сердечной пульсации, нечеткие контуры сердечной мышцы, ограничение подвижности ребер и др.
При неосложненной бронхиальной астме, особенно в легкой форме или в стадии ремиссии, на рентгене отклонений в структуре тканей легких видно не будет. Для заболевания средней и тяжелой степени характерны следующие изменения:
- увеличение площади воздушного пространства паренхимы (эмфизема легких);
- расширения правого отдела сердца;
- расширение отдельных участков в бронхах;
- сильное искривление грудной клетки и кифоз.
При остром приступе астмы также существуют характерные признаки, которые врач с легкостью распознает на рентгеновском снимке:
- одинаковая интенсивность при вдохе и выдохе;
- опущение диафрагмы;
- ребра больного располагаются перпендикулярно грудному отделу позвоночника;
- ширина межреберий сильно увеличивается;
- правый желудочка сердца сильно увеличен.
Именно благодаря изменениям в органах, которые видны на снимке, врач определяет стадию бронхиальной астмы и наличие осложнений. Благодаря точной диагностике пациенту подбирают эффективную схему лечения.
Рентгенологические признаки осложнений астмы и сопутствующих патологий
На рентгеновских снимках опытный специалист также может обнаружить, кроме бронхиальной астмы, признаки сопутствующих осложнений — воспаления легких, туберкулеза или онкологического заболевания.
Осложненная бронхиальная астма выглядит на рентген-снимке следующим образом:
- корни легких имеют большую ширину и плотность. Это указывает на воспалительный процесс в лимфатических узлах или отек;
- затемненные участки свидетельствуют об изменениях в легких, которые сопровождают развитие злокачественных образований или туберкулез;
- изменения в сосудистом рисунке органов дыхания.
Существуют и другие признаки, которые свидетельствуют об осложнениях и сопутствующих заболеваниях дыхательной системы. При их выявлении больного отправляют на дополнительные обследования, которые помогают поставить точный диагноз.
Другие методы диагностики бронхиальной астмы
Проверить функциональность легких пациента можно благодаря тесту на пиковую скорость вдыхаемого воздуха. Благодаря такому способу можно предположительно установить степень тяжести заболевания.
https://youtube.com/watch?v=Sx3JZD2MDUE
Еще одним современным методом обследования больных с астмой является компьютерная томография. Подтверждением диагноза является выявление аномальных изменений в сосудах легочной ткани. Такое обследование дорогостоящее и проводится не во всех медицинских учреждениях.
Дополнительные методы исследования включают также обследования органов желудочно-кишечного тракта, сердца, носоглотки и других органов и систем. Также больной сдает иммунологические анализы на уровень антител в организме.
В заключение
После подтверждения диагноза бронхиальной астмы пациенту подбирается эффективная схема лечения. Она включает прием определенных медикаментов, санаторно-курортное лечение, физиопроцедуры и т. д.
На стадии обострения пациента могут госпитализировать для купирования острых симптомов.
Больные с патологиями органов дыхания находятся на постоянном контроле врачей, проходя диагностику для своевременного выявления бронхиальной астмы.
Все исследования желательно проводить после прекращения приема медикаментозных препаратов. Это позволит увидеть достоверную картину, не искаженную симптоматическим лечением.
Флюорография, рентген и КТ при астме
При лечении бронхиальной астмы очень важна эффективная диагностика, благодаря которой можно не только подтвердить диагноз, но и определить основные особенности течения болезни. Поэтому для этих целей используются различные методы. Важной их частью являются инструментальные диагностические процедуры, такие как рентгенография, флюорография и компьютерная томография.
Основные инструментальные методы и результаты обследования
Рентген легких позволяет зафиксировать на снимке патологии органов дыхания. Он может показать очаговые уплотнения в тканях, а также рисунок сосудов в бронхах, что позволяет судить о наличии и распространении патологических процессов. Метод отличается простотой исполнения и высокой точностью.
Любые отклонения в области легких можно обнаружить с помощью рентгена, при этом на такое обследование не требуется много времени.
При компьютерной томографии производится послойное изучение легких. С ее помощью можно получить более точную информацию о недуге и обнаружить развивающиеся опухоли (если они есть). Данный метод является одним из самых новых и эффективных при диагностике самых разных патологий, в том числе и бронхиальной астмы. При наличии этого заболевания наблюдаются изменения сосудистого рисунка легких.
Флюорография является разновидностью рентгена. Это более простой и дешевый метод, поэтому его применяют при профилактических обследованиях.
Для диагностики непосредственно бронхиальной астмы он назначается редко, но благодаря ему удается обнаружить патологические процессы в легких даже тогда, когда отсутствуют симптомы болезни.
Если результаты флюорографии неблагоприятны, чаще всего требуется применение дополнительных методик обследования.
Инструментальные методы диагностики редко могут выявить астму без помощи лабораторных исследований, несмотря на их точность. Для правильного диагноза необходимо использовать их в комплексе с другими способами обследования.
Все три метода имеют общие черты. Как правило, и рентген, и флюорография, и компьютерная томография представляют собой снимок изучаемой области. Различается лишь техника их выполнения. Поэтому выводы о полученных результатах делаются сходным образом.
Лучше всего предоставить изучение снимка врачу. При отсутствии необходимых знаний очень трудно оценить показанный результат.
Рентгеновский (флюорографический) снимок легких без патологии можно обнаружить и без специальных знаний. На нем отсутствуют пятна, рисунок ровный, нет смазанности контуров. Все остальное говорит о наличии проблем (единственным исключением может оказаться брак пленки или ошибка в процессе обследования).
Поэтому врачи никогда не делают выводы лишь по одному исследованию. Если снимок демонстрирует наличие отклонений, обычно проводят повторное обследование. Иногда причина неблагоприятной картины на полученном снимке заключается в одном незначительном движении, которое совершил пациент в момент проведения процедуры.

Но зачастую любые отклонения от нормы могут показывать развитие болезни.
Какие отклонения можно диагностировать?
КТ, флюорографию и рентген при бронхиальной астме проводят и для выявления осложнений, а также других заболеваний бронхо-легочной системы. Данные методы позволяют диагностировать патологии разных органов. При обследовании легких любым из этих способов можно выявить:
- туберкулез;
- пневмонию;
- бронхит;
- патологии сердца;
- последствия травм грудной клетки;
- спаечные процессы;
- рак.
Все эти и другие заболевания может выявить только специалист, и для этого, наверняка, потребуются дополнительные исследования.
Снимки, сделанные в ходе таких исследований, могут демонстрировать различные типы отклонений, свидетельствующих, в том числе, и о развитии бронхиальной астмы и ее осложнениях. Это:
- Большая плотность или ширина корней легких говорит о том, что размеры лимфоузлов изменены, либо имеется отек. Чаще всего такой рисунок наблюдается при обследовании курящих людей, либо тех, кто занят на вредном производстве.
- Наличие тяжистых корней на рисунке является признаком хронического бронхита, сформированного у курильщика.
- При обнаружении единичного затемнения на снимке можно предположить развитие онкологического процесса.
- Несколько небольших затемнений тоже является отклонением от нормы. При их обнаружении можно предполагать наличие туберкулеза. Обычно врачи назначают повторное обследование, чтобы подтвердить или опровергнуть данный диагноз.
- Более яркое проявление сосудов на рисунке является признаком бронхита. Также такие результаты позволяют предполагать заболевания сердца.
- Изменения в сосудистом рисунке также могут свидетельствовать о развитии бронхиальной астмы, но этому диагнозу тоже требуется подтверждение.
- При наличии симптомов заболевания (кашель, одышка, хрипы), но отсутствии патологических явлений на снимке можно предполагать такой диагноз как бронхит.
Кроме перечисленных, данные методы диагностики могут выявлять и другие патологии.
Ставить диагноз должен врач, учитывая не только результаты проведенных процедур диагностики, но симптомы, проявляющиеся у пациента. Ни в коем случае не стоит делать выводы самостоятельно и приниматься за лечение.
Статья помогла вам?
Дайте нам об этом знать — поставьте оценку
Загрузка…